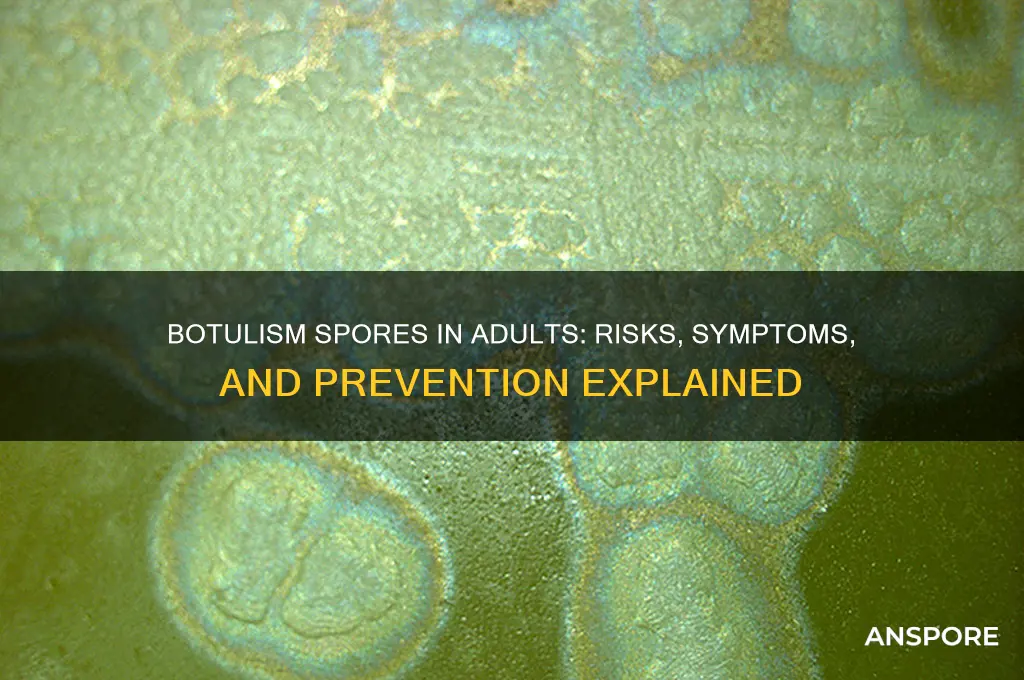
do botulism spores affect adults

Botulism, a rare but potentially fatal illness caused by the toxin produced by the bacterium *Clostridium botulinum*, is often associated with foodborne outbreaks. While it is commonly known that infants are particularly vulnerable to botulism due to their underdeveloped immune systems and intestinal flora, the question of whether botulism spores affect adults remains a topic of interest. Adults can indeed contract botulism, primarily through ingestion of contaminated food, inhalation of spores, or wound infection. However, their mature immune systems and established gut microbiota generally provide better protection against spore germination and toxin production compared to infants. Despite this, adults with compromised immune systems, gastrointestinal disorders, or those engaging in certain high-risk behaviors, such as injecting drugs, may face an increased susceptibility to botulism. Understanding the factors that influence adult susceptibility to botulism spores is crucial for prevention, diagnosis, and treatment strategies.
| Characteristics | Values |
|---|---|
| Can adults be affected by botulism spores? | Yes, adults can be affected by botulism spores, but the spores themselves are not harmful. It is the toxin produced by the spores in certain conditions that causes botulism. |
| How do botulism spores affect adults? | Spores can germinate and produce toxin in environments with low oxygen, low acidity, and suitable temperature (e.g., improperly canned food, wound infections). Ingesting the toxin or having it enter through wounds can lead to botulism. |
| Common sources of botulism in adults | Home-canned foods, contaminated wound sites, injection drug use, and, rarely, intestinal colonization in adults with altered gut microbiota. |
| Symptoms in adults | Muscle weakness, blurred vision, drooping eyelids, slurred speech, difficulty swallowing, dry mouth, and paralysis. Symptoms typically appear 12–36 hours after exposure but can take up to several days. |
| Severity in adults | Botulism can be life-threatening due to respiratory failure. Prompt medical treatment (e.g., antitoxin, supportive care) is critical. |
| Prevalence in adults | Rare but serious. Adults are less likely to develop infant botulism (intestinal colonization) unless they have specific risk factors (e.g., gut disorders). |
| Prevention in adults | Avoid consuming improperly canned or preserved foods, practice proper wound care, and refrain from injecting drugs. |
| Treatment for adults | Antitoxin administration, respiratory support, and intensive care if necessary. |
| Mortality rate in adults | With prompt treatment, the mortality rate is <5%, but delays increase the risk of complications and death. |
| Immunity in adults | Adults do not naturally develop immunity to botulism spores or toxin. Protection relies on prevention and proper food handling. |
Explore related products
$6.91 $14.03
What You'll Learn
- Spores in Food Sources: Common foods like canned goods, honey, and cured meats may harbor botulism spores
- Immune System Response: Healthy adults’ immune systems typically prevent spore germination and toxin production
- Risk Factors for Adults: Weakened immunity, gut disorders, or wounds can increase susceptibility to botulism
- Symptoms in Adults: Muscle weakness, blurred vision, difficulty swallowing, and paralysis are key indicators
- Prevention Strategies: Proper food handling, avoiding contaminated products, and prompt medical care reduce adult risk

Spores in Food Sources: Common foods like canned goods, honey, and cured meats may harbor botulism spores
Botulism spores, though ubiquitous in soil and sediment, pose a significant risk when they find their way into certain food sources. Canned goods, honey, and cured meats are prime examples of foods that can harbor these spores. The danger lies not in the spores themselves but in the toxin they produce when conditions are right—anaerobic environments, warmth, and a low-acid food matrix. For instance, home-canned vegetables or improperly processed meats can become breeding grounds for *Clostridium botulinum*, the bacterium responsible for botulism. Adults, unlike infants, are generally not at risk from honey consumption due to their mature digestive systems, but other contaminated foods can still pose a threat.
Consider the process of canning: if jars are not sterilized correctly or if the food is not heated to a sufficient temperature (typically 240°F or higher), spores can survive and germinate. Similarly, cured meats like salami or jerky, which rely on drying and salt for preservation, may not always eliminate spores entirely. Even a small amount of toxin—as little as 0.00005 milligrams—can cause severe symptoms in adults, including paralysis and respiratory failure. This underscores the importance of following USDA-approved canning and food preservation guidelines, such as using pressure canners for low-acid foods and ensuring proper sealing of jars.
Honey, often considered harmless, is a less obvious culprit. While botulism spores in honey rarely affect adults, they can be dangerous for infants under one year old, whose digestive systems are not yet equipped to neutralize the spores. This highlights a critical distinction: the risk to adults lies primarily in other food sources, particularly those prepared at home without commercial sterilization methods. For example, artisanal or homemade canned goods, smoked fish, and fermented foods like garlic-in-oil mixtures are common offenders. These foods often lack the rigorous safety protocols of commercial production, making them potential hazards.
To mitigate risk, adults should adhere to specific practices. When preparing canned goods, always use a pressure canner for low-acid foods like vegetables and meats, and boil high-acid foods (e.g., fruits, pickles) for at least 10 minutes to destroy spores. Avoid consuming bulging cans or jars with loose lids, as these are signs of potential contamination. For cured meats, ensure they are sourced from reputable suppliers who follow FDA or USDA guidelines. Finally, store all foods at appropriate temperatures—below 40°F for refrigeration and above 140°F for hot-holding—to prevent spore germination. By understanding the risks and taking proactive measures, adults can safely enjoy these foods while minimizing the threat of botulism.
Do Seed Plants Disperse Spores? Unraveling Plant Reproduction Mysteries
You may want to see also

Immune System Response: Healthy adults’ immune systems typically prevent spore germination and toxin production
Healthy adults rarely succumb to botulism because their immune systems are adept at thwarting the threat before it begins. Botulism spores, which are the dormant forms of the bacterium *Clostridium botulinum*, are ubiquitous in soil, dust, and even some foods. However, these spores require specific conditions—such as a low-oxygen environment and a protein-rich medium—to germinate and produce the potent neurotoxin that causes botulism. For most adults, the immune system acts as a vigilant gatekeeper, recognizing and neutralizing spores before they can establish a foothold. This innate defense mechanism is a critical reason why botulism cases in healthy adults are exceedingly rare, with the majority occurring in infants or individuals with compromised immunity.
The immune system’s role in preventing botulism is multifaceted. When botulism spores enter the body, they encounter a barrage of defenses, including stomach acid, which can destroy many spores before they reach the intestines. Even if some spores survive, the immune system’s phagocytic cells—such as macrophages and neutrophils—identify and engulf them, preventing germination. Additionally, the gut microbiome in healthy adults often outcompetes *C. botulinum* for resources, further limiting its ability to thrive. This layered defense explains why adults can ingest botulism spores without consequence, while infants, whose immune and digestive systems are still developing, are far more susceptible.
To illustrate, consider the case of home-canned foods, a common source of botulism spores. Adults who consume improperly canned vegetables or meats may ingest spores, but their immune systems typically prevent these spores from germinating and producing toxin. In contrast, infants under 12 months old are at higher risk because their stomach acidity is lower, and their immune systems are less mature. This is why health authorities strongly advise against feeding honey—which can contain botulism spores—to infants. For adults, the risk is minimal, provided their immune systems remain robust.
Practical steps can further reduce the already low risk of botulism in adults. Proper food handling, such as boiling home-canned foods for 10 minutes before consumption, can destroy any toxins present. Avoiding dented or swollen cans and refrigerating oils infused with garlic or herbs can also prevent spore germination. While these precautions are important, they underscore a broader truth: for healthy adults, the immune system is the primary and most effective defense against botulism. Understanding this dynamic empowers individuals to focus on maintaining overall immune health, ensuring their bodies remain equipped to handle such threats effortlessly.
Can Spore Biotics Overgrow? Balancing Benefits and Potential Risks
You may want to see also

Risk Factors for Adults: Weakened immunity, gut disorders, or wounds can increase susceptibility to botulism
Botulism, caused by the toxin produced by *Clostridium botulinum* spores, is often associated with foodborne illness, but its impact on adults extends beyond contaminated meals. While healthy adults typically have robust defenses against botulism spores, certain conditions can tip the scales, increasing susceptibility to this potentially life-threatening disease. Weakened immunity, gut disorders, and wounds are key risk factors that demand attention, as they create environments where botulism spores can germinate and produce toxin.
Consider the immune system, the body’s first line of defense. Adults with compromised immunity—whether due to HIV/AIDS, chemotherapy, autoimmune disorders, or long-term steroid use—face heightened risk. For instance, a 50-year-old cancer patient undergoing chemotherapy may have a suppressed immune system, making it easier for botulism spores to colonize the gut and produce toxin. Practical steps for this group include avoiding high-risk foods like improperly canned goods, honey (which should never be given to infants but is generally safe for adults), and vacuum-packed fish. Regular medical check-ups and adherence to prescribed treatments can also mitigate risk.
Gut disorders, such as inflammatory bowel disease (IBD) or chronic constipation, disrupt the intestinal environment, creating conditions favorable for spore germination. For example, a 40-year-old with Crohn’s disease might experience altered gut flora, reducing the natural competition that keeps *C. botulinum* in check. In such cases, dietary modifications—like increasing fiber intake to regulate bowel movements or avoiding foods that exacerbate gut inflammation—can be protective. Probiotics, under medical supervision, may help restore a healthy gut microbiome, though their role in botulism prevention is still under study.
Wounds, particularly deep or punctured injuries, provide another entry point for botulism spores. Adults with diabetes, for instance, are prone to slow-healing wounds, which can become breeding grounds for *C. botulinum* if contaminated with soil or dust. A 60-year-old diabetic with a foot ulcer should meticulously clean and dress wounds, ensuring they remain free from environmental contaminants. Antibiotic prophylaxis, as prescribed by a healthcare provider, may also be necessary to prevent infection.
In summary, while botulism spores are ubiquitous, adults with weakened immunity, gut disorders, or wounds face elevated risks. Tailored precautions—such as dietary adjustments, wound care, and immune support—can significantly reduce susceptibility. Awareness of these risk factors empowers individuals to take proactive steps, turning vulnerability into vigilance.
Sporulation Timing: How and When Spore-Forming Bacteria Initiate the Process
You may want to see also
Explore related products

Symptoms in Adults: Muscle weakness, blurred vision, difficulty swallowing, and paralysis are key indicators
Botulism, a rare but severe illness caused by the bacterium *Clostridium botulinum*, can affect adults through ingestion of contaminated food, inhalation, or wound infection. While botulism spores themselves are generally harmless, they can germinate in favorable conditions, producing toxins that lead to life-threatening symptoms. Adults are not immune to these effects, and recognizing the early signs is critical for prompt treatment. Among the most alarming symptoms are muscle weakness, blurred vision, difficulty swallowing, and paralysis—indicators that the toxin is disrupting nerve function and muscle control.
Muscle weakness often begins subtly, with a feeling of heaviness in the limbs or difficulty performing routine tasks like lifting objects or climbing stairs. This symptom progresses rapidly, typically within 12 to 36 hours after exposure, depending on the toxin dose. For instance, foodborne botulism from improperly canned foods can introduce as little as 0.001 to 0.01 micrograms of botulinum toxin, sufficient to cause systemic effects in adults. Monitoring for weakness, especially in the arms and legs, is crucial, as it signals the toxin’s interference with neuromuscular junctions.
Blurred vision and difficulty swallowing are early neurological symptoms that often accompany muscle weakness. These occur as the toxin paralyzes the muscles responsible for eye movement and the esophagus. Adults may notice double vision, drooping eyelids (ptosis), or a sensation of food "sticking" in the throat. These symptoms are not merely inconvenient—they are red flags indicating potential respiratory compromise, which can be fatal if untreated. Immediate medical attention is essential, as antitoxins like botulism antitoxin heptavalent (BAT) can neutralize circulating toxins if administered early.
Paralysis is the most severe manifestation of botulism in adults, progressing from localized muscle weakness to full-body involvement. It typically starts in the head and neck, affecting facial muscles and speech, before descending to the limbs and respiratory muscles. Adults with botulism may experience slurred speech, inability to smile, or difficulty breathing, requiring mechanical ventilation in severe cases. The risk of paralysis underscores the importance of recognizing earlier symptoms and avoiding delays in seeking care. For example, wound botulism in adults, often linked to intravenous drug use, can progress rapidly if the wound is not cleaned and treated promptly.
Practical tips for adults include avoiding consumption of home-canned foods that appear swollen or smell foul, as these are common sources of botulism spores. Wounds, especially those exposed to soil, should be thoroughly cleaned and monitored for signs of infection. If symptoms like muscle weakness or blurred vision appear after consuming questionable food or sustaining an injury, seek emergency care immediately. Early diagnosis and treatment, including antitoxins and supportive care, significantly improve outcomes, reducing the risk of long-term complications or fatality.
Do Angiosperms Reproduce by Spores? Unraveling Plant Reproduction Myths
You may want to see also

Prevention Strategies: Proper food handling, avoiding contaminated products, and prompt medical care reduce adult risk
Botulism spores, though ubiquitous in soil and sediment, rarely pose a threat to adults when proper precautions are taken. The key to minimizing risk lies in understanding how these spores transform into the toxin that causes botulism—a process that occurs in anaerobic, low-acid environments, such as improperly canned foods or vacuum-sealed products. For adults, who generally have stronger immune systems than infants, the danger arises not from the spores themselves but from ingesting the toxin they produce. This distinction highlights the importance of targeted prevention strategies.
Proper food handling is the first line of defense. Adults should adhere to strict guidelines when preparing and storing food, particularly home-canned goods. The USDA recommends boiling low-acid foods (like vegetables, meats, and fish) for at least 10 minutes before consumption to destroy any botulinum toxin. Pressure canning at 240°F (116°C) is essential for these items, as standard boiling water baths are insufficient. For commercially canned products, inspect cans for bulging, leaks, or foul odors—signs of potential contamination. Avoid consuming food from damaged containers, even if it appears safe.
Avoiding contaminated products requires vigilance and education. Certain foods, such as honey, should never be given to infants under one year due to the risk of botulism spores, but adults can safely consume them. However, adults should steer clear of illicit or improperly prepared foods, such as homemade infused oils or fermented dishes made without proper acidity levels. For instance, garlic-in-oil mixtures must include pH-lowering agents like vinegar or be refrigerated to prevent spore germination. Commercially produced items are regulated to ensure safety, but homemade versions often lack these safeguards.
Prompt medical care is critical if botulism is suspected. Adults experiencing symptoms like blurred vision, difficulty swallowing, or muscle weakness should seek immediate treatment. Botulism is a medical emergency, and early administration of antitoxin can prevent progression. While rare, adult cases often stem from foodborne sources, making it essential to report recent dietary history to healthcare providers. Timely intervention not only improves outcomes but also reduces the risk of long-term complications, such as prolonged paralysis or respiratory failure.
In summary, adults can significantly reduce their risk of botulism by adopting specific prevention strategies. Proper food handling, particularly in home canning and storage, eliminates conditions conducive to toxin production. Avoiding contaminated products, especially those prepared without regulatory oversight, further minimizes exposure. Finally, recognizing symptoms and seeking prompt medical care ensures that even in rare cases of exposure, the disease can be managed effectively. These measures collectively form a robust defense against botulism in adulthood.
Contaminated Fruits: Can You Safely Harvest Spores from Them?
You may want to see also
Frequently asked questions
Yes, botulism spores can affect adults. While botulism is rare, adults can become infected if they ingest preformed botulinum toxin or if spores germinate and produce the toxin in the intestines, leading to symptoms like muscle weakness, blurred vision, and difficulty breathing.
Adults are generally less susceptible to botulism from spores compared to infants. Adult intestines are less favorable for spore germination, and their immune systems are better equipped to handle potential exposure. However, adults can still contract botulism through contaminated food or wounds.
Botulism spores in food can pose a risk to healthy adults if the spores germinate and produce toxin in improperly stored or prepared food. Canned, fermented, or preserved foods are common sources. Proper cooking and storage practices can significantly reduce the risk of botulism in adults.































